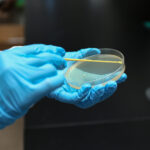

1µl Inoculating Loop, Blue, Individually Wrapped, sterile 400/pk, 4000/cs
$390.00
Nest 1µl Inoculating Loop, Blue, Individually Wrapped 717101
• PP material, hydrophilic
• Used in microbiology experiments
• Different colors for identification
• Flexible handles for easier collection and inoculation
• Sterilized by Ethylene Oxide
• Easy-tear sterile individual packaging
- Details & Specifications
- References
| Catalog No. | 717101 |
|---|---|
| Product Name | 1µl Inoculating Loop, Blue, Individually Wrapped, sterile 400/pk, 4000/cs |
| Supplier Name | Nest Scientific |
| Brand Name | Nest Scientific |
| Qty/Pk | 4000 |
| Qty/Cs | 400 |
| Tag | Inoculating Loop, Blue, sterile |
| Weight (KG) | 10.15 |
| L (m) | 0.56 |
| W (m) | 0.31 |
| H (m) | 0.33 |
| Volume (m3) | 0.057 |
| Weight (LB) | 22.38 |
| L (in) | 22 |
| W (in) | 12 |
| H (in) | 13 |
| Note | Products will be shipped from the warehouse in New Jersey or Arizona depending on location to deliver. Promotion is running from time to time. Welcome to send a request for quote to message@sydlabs.com. |
| Order Offline | Syd Labs, Inc. 4 Avenue E, Hopkinton, MA 01748 USA. Phone: 1-617-401-8149 Fax: 1-617-606-5019 Email: message@sydlabs.com |
Description
717101: 1µl Inoculating Loop, Blue, Individually Wrapped, sterile 400/pk, 4000/cs
Please remember our product information: 1µl Inoculating Loop, Blue, Individually Wrapped, sterile 400/pk, 4000/cs: 717101 Nest